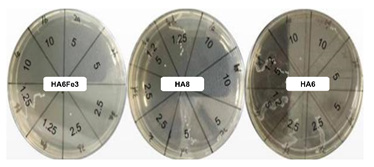

Research Article
Creative Commons, CC-BY
Effects of Aliphatic Hydroxamic Acids and Their Iron (III) Complex Against Enterococcus Faecalis and Candida Krusei
*Corresponding author: Rongshan Li, Department of Nephrology, Fifth Hospital of Shanxi Medical University (Shanxi Provincial People’s Hospital), Shanxi Kidney Disease Institute, Taiyuan 030012, China.
Received: December 06, 2024; Published: December 13, 2024
DOI: 10.34297/AJBSR.2024.25.003289
Abstract
To further investigate our previous studies concerning the biological properties of aliphatic Hydroxamic Acids (HA) and their iron (III) complexes, we determine the effect of HA and their complexes against bacteria (Enterococcus faecalis) and fungal (Candida krusei). Two HA (N-hydroxyhexanamide (HA6) and N-hydroxyoctanamide (HA8)) and a complex (trihydroxamato-iron (III) (HA6Fe3)) were used to assess the impact against E. faecalis and C. krusei. The Minimum Inhibitory Concentration (MIC) and Minimum Bactericidal Concentration (MBC) were determined by microdilution method. Compound HA8 showed a more effective antibacterial and antifungal action than its shorter carbon chain counterpart (HA6) on experimental strains. The effect of the complex HA6Fe3 was similar to the HA8 compound against E. faecalis. The antibacterial and antifungal effects observed with compounds HA6, HA8 and HA6Fe3 against E. faecalis and C. krusei are in agreement with our previous published studies into the effect of carbon chain length and complexation.
Keywords: Hydroxamic acids, Iron complex, Enterococcus faecalis, Candida krusei
Introduction
The 21st century has witnessed rapid development in life sciences, with the research and development of drugs reaching unprecedented prosperity. Notably, the development of antimicrobial drugs has increasingly become a research hotspot for scientists. Antimicrobial drugs are widely used in clinics to control microbial infectious diseases. However, the irrational use of drugs in clinics easily leads to the emergence of drug - resistant bacterial strains, making bacterial resistance to antimicrobial drugs a global public health problem [1]. Drug sensitivity testing is the most commonly used in vitro research method for studying drug sensitivity, mainly reflecting the degree of bacterial resistance. It is the main content of antimicrobial pharmacology and also the main basis for clinical drug use. Although traditional methods for screening effective antibiotics have achieved great success, these methods are cumbersome, labor - intensive, and poorly targeted. It is difficult to develop new antimicrobial drugs if traditional methods are continuously followed. Currently, scholars from various countries are committed to replacing random classical selection with rational selection with a clear purpose. The screening method for new antimicrobial drugs will be based on the genome and proteomic analysis of the main pathogenic bacteria to identify potential drug targets. New types of chemical drugs will be synthesized through chemical methods, or existing chemical drugs will be modified (such as functional groups, carbon chains, etc.), or auxiliaries (such as matrices) will be added during the synthesis process to change the drug absorption mode and reduce side effects [2]. In addition, the active ingredients of natural medicines, especially Chinese medicines, provide a rich source for drug selection. For example, Professor Hao Wen, a renowned snake venom researcher in China, once extracted earth kinase from Zhejiang pit vipers, which has shown significant efficacy in the clinical treatment of vascular diseases. Given the rapid reproduction rate of microorganisms and the ease of cultivation and fermentation, there is no doubt that drugs derived from microorganisms will have a broader future.
Bacterial infections include both hospital - acquired and community- acquired infections. The most common cause of community- acquired infections is the Gram-positive bacteria Enterococcus faecalis (E. faecalis). E. faecalis is part of the normal flora in the intestinal tract of animals and is usually considered harmless to animal or human organisms, being a commensal organism. However, recent studies have demonstrated that some E. faecalis have acquired multiple virulence genes, such as esp, acm, and hyl, during long - term evolution, which can cause a wide range of infections [3]. In recent years, the treatment of E. faecalis infections has faced significant challenges due to the increasing antibiotic resistance resulting from the long - term and excessive use of antibiotics [4]. Candida krusei (C. Krusei) is a common genus of normal flora. Human infections usually do not affect the patient’s life and work [5,6]. However, with increasing age, especially in the elderly, the body’s immune function declines, making individuals more susceptible to Candida infections. Studies have shown that Candida infections have no gender differences and can affect all age groups, including the fetus. The infection can invade almost all tissues and organs of the body [7]. In clinical practice, Candida infections can involve multiple systems or organs of the body, leading to disseminated candidiasis, including Candida bloodstream infection [8]. Therefore, timely and accurate selection of effective antibiotics is crucial for successful treatment. However, clinical treatment often requires a waiting period due to difficulties in early - stage infection screening, blood culture strain identification, and prolonged drug susceptibility testing. As a result, the best opportunity for treatment is often delayed, and many new and distinctive antimicrobials are being developed and produced. Chemically synthesized hydroxamic acids derivatives have been reported to have some inhibitory effects on common clinical pathogens and may be potential antimicrobial agents [9]. In the present study, we analyzed the effects of the N-hydroxyhexanamide (HA6), N-hydroxyoctanamide (HA8) and tri-hexanohydroxamato- iron (III) (HA6Fe3) Figure 1 against the growth of E. faecalis and C. krusei. The Minimum Inhibitory Concentration (MIC) and Minimum Bactericidal Concentration (MBC) was determined, thereby evaluating the potential value of compounds HA6, HA8 and HA6Fe3 Figure 1 as novel antibacterial drugs for chemical research and development and clinical use. The determination of MIC and MBC was aimed at evaluating the potential value of HA and their iron (III) complex as novel antimicrobial drugs and providing an experimental basis for the research and development of chemical drugs and the clinical use of antimicrobials (Figure 1).
Figure 1: Chemical structures of N-hydroxyhexanamide (HA6), N-hydroxyoctanamide (HA8) and tri-hexanohydroxamato-iron (III) (HA6Fe3).
Materials
The standard strains of Enterococcus faecalis (ATCC 29212) and Candida krusei (ATCC 6258) were maintained in the microbiology laboratory of Shanxi Provincial People’s Hospital. The compounds HA6, HA8 and HA6Fe3 (Figure 1) were synthesized in microbiology, bioorganic and macromolecular chemistry unit, Faculty of Pharmacy, Université Libre De Bruxelles (ULB). The main reagents utilized in the study consisted of M-H broth (Qingdao Hi-Tech, China), Dimethyl Sulfoxide (DMSO, Sinopharm, China), Methyl Thiazolyl Tetrazolium (MTT, Nanjing Diensel Biotechnology Co., Ltd.), and Tryptone Soya Agar (TSA, Qingdao Hi-Tech, China). Key equipment included an incubator set at 35±2°C (GHP-9050), a biological safety cabinet (HFsafe-1500TE), an autoclave (DGL-100B), micro-sampling apparatuses (WKYII-2, WKYII-20), a VITEK turbidimeter (WZB-175).
Methods
Synthetic Method of HA and Complex: The synthetic method for compounds (HA6, HA8 and HA6Fe3) and their characterization by IR, UV, 1H and 13C NMR, elemental analysis and including structural determination by single crystal X-ray diffraction were reported in our previous work [10,11].
Culture Medium Preparation: Weighing 40.0 g of TSA or 21.0g of Mueller Hinton broth (MH) powder, respectively, into 1000mL distilled water, heating and stirring to dissolved, autoclaved and sterilized for 15 minutes, and then store it at 2-8°C. Preparation of Bacterial Suspension: The preculture of E. faecalis and C. krusei were grown on the blood agar medium plate. One day before the experiment, pick a few colonies and inoculate them into the TSA medium petri dishes for culturing at 37°C for 18- 20h. On the next day, scrape the single colonies on the petri dishes with a cotton swab, inoculate them into test tubes containing sterile distilled water, adjust the optical density at 600 nm (OD600) with 0.6, and take 0.2 mL of the bacterial suspension into a tube containing 19.8 mL of distilled water used for further investigation.
Preparation of Antimicrobials Compounds: Weigh HA6Fe3, HA6, and HA8 and dissolve them in DMSO. The details are as follows: weigh 0.027 g of HA6 and dissolve it in 0.27 mL of DMSO; 0.022 g of HA8 dissolved in 0.22 mL of DMSO; 0.012 g of HA6Fe3 dissolved in 0.12 mL of DMSO, with the final concentration of all drug samples being 100 mg/mL.
Determination of Minimum Inhibitory Concentration (MIC): To assess drug sensitivity, the broth dilution method was employed to determine the MIC of compounds HA6, HA8 and HA6Fe3 against E. faecalis and C. krusei. All procedures involving 96-well cell culture plates, including the preparation of antimicrobial agents, bacterial suspensions, drug dilutions, and inoculum concentrations, strictly adhered to relevant industry standards. Briefly, using the microdilution method, add 80μL of MH liquid culture medium to well NO.1 of the 96-well plate, 50μL to wells 2-8, and 100μL to wells NO.11-12. Introduce 20μL of the drug sample solution into well NO.1 and mix thoroughly. Next, aspirate 50μL from well NO.1 and transfer it to well NO.2, performing successive serial dilutions through to well NO.8. Add 50μL of bacterial suspension to wells NO.1-10. The compounds were diluted with a final concentrations of 0.08, 0.16, 0.32, 0.63, 1.25, 2.5, 5, and 10 mg/mL. Wells NO.9-10 will serve as positive controls with the same bacterial suspension in MH liquid medium, while wells NO.11-12 will be negative controls containing only MH liquid medium. After inoculation, incubate the 96-well plates for 24 hours. Following this, add 30 μL of MTT to each well and place the plates in a light-proof environment for 1 hour. The experiment will be conducted in triplicate. Results will be evaluated visually; if any wells appear clear and transparent, bacterial growth is considered inhibited. The lowest drug concentration present in these clear wells will be designated as the MIC for the tested bacteria.
Determination of Minimum Bactericidal or Fungicidal Concentration (MBC or MFC): To determine the MBC or MFC, all concentrations from the 96-well plates that exhibit inhibitory effects on bacterial growth are inoculated onto TSA medium. A sterile inoculation loop is used to gently spread the inoculum across the agar surface. The inoculated TSA plates are then incubated at 37°C for 24 hours. After incubation, the plates are examined for bacterial growth; the MBC or MFC is defined as the lowest antibiotic concentration that kills at least 99.9% of the bacteria or fungi.
Results
In the present study, the MIC and MBC or MFC were determined using the microdiluted method (Table 1).
Table 1: The MIC and MBC or MFC determination for E. faecalis and Candida kruse with compounds HA6Fe3, HA8 and HA6.
The bacteria in the positive control groups (without drugs) showed good growth manner, and the negative control (culture medium only) showed without bacterial growth. For further assess the impact of the DMSO on the experimental microrganism growth, the bacteria in the diluted DMSO-culture medium were also growing in good manner, suggesting that the DMSO with highest experimental concentration (25%, v/v) can not impact bacteria growth. The blank control showed no bacterial growth, indicating that the experiment was standardized, free of contamination and the data were valid (Figure 2). For MBC or MFC determination, we observed that the bacterial colonies at 1.25 mg/mL and one colony at 2.5 mg/ mL for HA6Fe3, at 1.25-5 mg/mL for HA8 and at 1.25-10 mg/mL for HA6, respectively (Figure 3).
Discussion
E. faecalis is a facultative anaerobic, Gram-positive bacteria that lacks spores and capsules [12]. It is commonly found as part of the normal flora in the intestines of animals and is generally considered a commensal bacteria [13]. However, recent studies have confirmed that some E. faecalis have acquired virulence genes during long - term evolution, which may lead to widespread infections. Furthermore, the increasing resistance of E. faecalis to antibiotics is a growing concern, largely due to the extensive and improper use of non-standard antibiotics. C. krusei is another pathogen that can cause infections, affecting individuals regardless of gender and impacting all age groups, including unborn fetuses. The infection can involve nearly all tissues and organs in the body, with disseminated candidiasis affecting multiple systems, including bloodstream infections. The normal balance of the body’s flora may be disrupted by the use of antibiotics and hormonal medications [7]. Timely and accurate selection of effective antibiotics is crucial for successful treatment; however, initiating treatment often requires a waiting period due to diagnostic challenges.
From a biological perspective, E. faecalis is a prokaryotic bacteria without a nucleus, whereas C. krusei is a eukaryotic fungus that possesses a nucleus and various organelles. In hospital settings, bacterial infections are generally more common, while fungal infections, mainly opportunistic ones, tend to occur less frequently, particularly in immunocompromised patients [14], such as those undergoing chemotherapy for AIDS or taking other immunosuppressive drugs. The treatment modalities for bacterial and fungal infections differ significantly; antibacterial drugs are used for bacteria, while antifungal medications are required for fungi. With the misuse of broad-spectrum antibiotics, the resistance of Gram-positive cocci continues to rise annually, leading to an urgent need for research on compounds with antimicrobial activity that could replace or supplement existing antibiotics.
Hydroxamic Acid (HA) and its complexes demonstrated effective inhibitory effects against a wide range of fungi. According to the M100-S22 standards set by the Clinical and Laboratory Standards Institute (CLSI), a microorganism is considered tolerant to a drug if the MBC to MIC ratio is ≥32 [15]. In this study, we evaluated the MIC and MBC or MFC of HA (HA6 and HA8) and iron (III) complexe (HA6Fe3) against E. faecalis and C. krusei. The results indicated that these compounds possess significant antimicrobial efficacy and varying degrees of bactericidal activity. Notably, HA6Fe3, HA8, and HA6 exhibited antibacterial properties against both pathogens, with compound HA8 showing the strongest activity. Specifically, its MIC and MBC against E. faecalis were determined to be 0.63 mg/ mL and 1.25 mg/mL, respectively, while its MIC and MFC against C. krusei were both <0.08 mg/mL.
In the course of this experiment, due to the limited experimental conditions, experimental errors could not be avoided. For example after the addition of MTT in this experiment, the longer the plates were placed in the light, the more obvious the inhibition effect of the drug against E. faecalis. Due to the slower growth rate of C. krusei, it took longer to obtain single colonies of C. krusei than that of E. faecalis. Therefore, the antimicrobial and fungicidal activity of compound HA8, against C. Krusei, needs to be further investigated in depth, for instance, proteomic analysis to screen the potential targets. The results of the present study all suggest that the synthesis drugs of HA and their complexe have good bactericidal or fungicidal ability and antimicrobial effect against E. faecalis and C. krusei infections and are expected to be used in the clinical treatment of E. faecalis and C. krusei infections, providing more alternative treatment options.
Conclusion
The study of the antibacterial and antifungal effect of compounds HA6, HA8 and HA6Fe3 showed:
i. Compound HA8 (MIC < 0.08 mg/mL) was more active than its counterpart HA6 (MIC=0.16-0.32 mg/mL) against C. krusei (Table 1). Similar results were obtained with E. faecalis where compound HA8 was more active than HA6. These results further support our previously published results [10]. Indeed, hydrophilicity due to the length of the HA carbon chain is a key factor in biological activity [10]
ii. As for the complex HA6Fe3, the results show that it is more active than its corresponding HA (HA6) against E. faecalis (Table 1). These results are in agreement with those reported in the literature where complexation is claimed to improve the biological activity of HA [10]. However, the opposite results were obtained with the fungal strain, with compound HA6 being more active than its corresponding complex (HA6Fe3) against C. krusei (Table 1). The results of this research show a much improved fungicidal than the bactericidal effect observed with compounds HA6, HA8 and HA6Fe3 against C. krusei and E. faecalis. These compounds are promising in the development of new antifungal and antibacterial agents (Table 1).
Conflict of Interest Statement
The authors declare no conflicts of interest. The authors declare that the research was conducted in the absence of any commercial or financial relationships that could be construed as a potential conflict of interest.
Acknowledgements
None.
References
- R Laxminarayan, A Duse, C Wattal, A K M Zaidi, H F L Wertheim, N Sumpradit, et al. (2013) Antibiotic resistance-the need for global solutions. Lancet Infect Dis 13(12): 1057-1098.
- A C Flick, H X Ding, C A Leverett, R E Kyne, K K C Liu, S J Fink, et al. (2017) Synthetic Approaches to the New Drugs Approved during 2015. J Med Chem 60(15): 6480-6515.
- Y Wei, D P Araya, K L Palmer (2024) Enterococcus faecium: evolution, adaptation, pathogenesis and emerging therapeutics. Nat Rev Microbiol 22(11): 705-721.
- L Guan, M Beig, L Wang, T Navidifar, S Moradi, F Motallebi Tabaei, et al. (2024) Global status of antimicrobial resistance in clinical Enterococcus faecalis isolates: systematic review and meta-analysis. Ann Clin Microbiol Antimicrob 23(1): 80-95.
- S A Turner, G Butler (2014) The Candida pathogenic species complex. Cold Spring Harb Perspect Med 4(9): 1-17.
- A T Jamiu, J Albertyn, O M Sebolai, C H Pohl (2021) Update on Candida krusei, a potential multidrug-resistant pathogen. Med Mycol 59(1): 14-30.
- C Spampinato, D Leonardi (2013) Candida infections, causes, targets, and resistance mechanisms: Traditional and alternative antifungal agents. Biomed Res Int 2013: 1-13.
- A M Paixao de Sousa da Silva, M I de Moraes Pinto, L Teofilo Pignati, B Barbosa Teixeira, A P Cordeiro Lima, P Costa Pimentel Germano, et al. (2020) Candida spp bloodstream infections in a Latin American Pediatric Oncology Reference Center: Epidemiology and associated factors. Mycoses 63(8): 812-822.
- A Citarella, D Moi, L Pinzi, D Bonanni, G Rastelli (2021) Hydroxamic Acid Derivatives: From Synthetic Strategies to Medicinal Chemistry Applications. ACS Omega 6(34): 21843-21849.
- I S Sow, M Gelbcke, F Meyer, M Vandeput, M Marloye, S Basov, et al. (2023) Synthesis and biological activity of iron (II), iron (III), nickel (II), copper (II) and zinc (II) complexes of aliphatic hydroxamic acids. J Coord Chem 76(1): 76-105.
- I S Sow, M Gelbcke, F Dufrasne, K Robeyns (2023) Crystal structures of a series of hydroxamic acids, Molbank 2023(2023): 8-13.
- D Shah, S Varahan (2024) Enterococcus faecalis. Trends Microbiol 32(9): 925-926.
- M S Saïd, E Tirthani, E Lesho (2024) Enterococcus Infections. In: StatPearls [Internet]. Treasure Island (FL): StatPearls Publishing; 2024 Jan.
- A Sikora, F Zahra (2024) Nosocomial Infections. In: StatPearls [Internet]. Treasure Island (FL): StatPearls Publishing; 2024 Jan.
- N Gonzalez, D Sevillano, L Alou, F Cafini, M J Gimenez, M L Gomez Lus, et al. (2013) Influence of the MBC/MIC ratio on the antibacterial activity of vancomycin versus linezolid against methicillin-resistant Staphylococcus aureus isolates in a pharmacodynamic model simulating serum and soft tissue interstitial fluid concentrations reported in diabetic patients. J Antimicrob Chemother 68(10): 2291-2295.

We use cookies to ensure you get the best experience on our website.